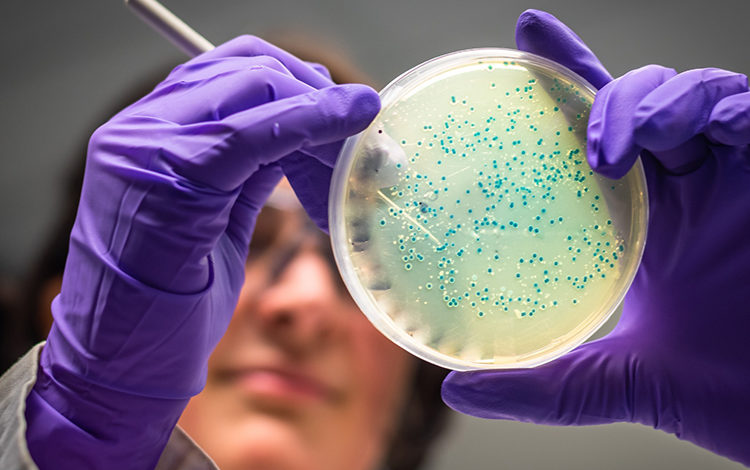

Huzursuz bağırsak sendromu tedavisinde %78 başarıya ulaşıldı
Türkiye’de yaşayan insanların yaklaşık %15’inin muzdarip olduğu Hassas Bağırsak Sendromu’un tedavi desteğine yönelik yapılan klinik çalışmada önemli bir başarıya imza atıldı. İnsan bağırsağındaki bakterileri mikrobiyom testleriyle analiz ederek kişisel beslenme programları geliştiren yerli biyoteknoloji girişimi ENBIOSIS’in yürüttüğü klinik çalışmada Huzursuz Bağırsak Sendromu hastalarının %78’inde semptomlarda iyileşme gözlemlendi.
Bağırsakta yer alan ve mikrobiyom elamanları olarak adlandırılan bakterilerin insan sağlığıyla ilişkisine yönelik araştırmalar tüm dünyada hız kazanarak devam ediyor. Bu alanda yürütülen araştırmaların içerisinde yer alarak insan bağırsağındaki bakteriler üzerinden obezite, diyabet ve egzama gibi pek çok sağlık sorununun tedavisi için kişiye özel sağlık çözümleri geliştirmeyi hedefleyen yerli biyoteknoloji girişimi ENBIOSIS, halk arasında Huzursuz Bağırsak Sendromu olarak bilinen IBS üzerine yaptığı klinik çalışmayla önemli bir başarıya imza attı. ENBIOSIS tarafından yapılan açıklamada kişiye özel diyetlerin uygulandığı IBS hastalarının %78’inin semptomlarında iyileşme gözlendiği bildirildi. Bu sonuç, mikrobiyom temelli diyet uygulamasının IBS tedavisi üzerinde umut vadedebileceğine dair önemli bir bilimsel çıktı olarak değerlendirildi.
Gazi Üniversitesi’nden etik kurul onayı alındı
Klinik çalışmanın detaylarını aktaran ENBIOSIS CTO’su Özkan Ufuk Nalbantoğlu, “Gazi Üniversitesi’nden alınan etik kurul onayı ile yürüttüğümüz çalışmamamızın ilk aşamasında, Huzursuz Bağırsak Sendromu tanılı çalışmaya katılım kriterlerini sağlayan hastalardan dışkı örnekleri toplandı ve mikrobiyom analizleri gerçekleştirildi. Daha sonra hastalar iki gruba ayırıldı ve ilk grup ENBIOSIS’in geliştirdiği mikrobiyoma dayalı kişiselleştirilmiş diyet ile diyetisyenler tarafından 6 hafta boyunca takip edildi. İkinci grup, yani kontrol grubu ise 6 hafta boyunca standart beslenme programıyla takip edildi. Özellikle belirtmek isterim ki, ENBIOSIS diyet grubunda beslenme programları IBS tedavilerinde genel kabul gören eliminasyon diyetlerine göre değil, mikrobiyoma dayalı bireysel bazda ve alternatifli bir şekilde oluşturuldu. Bu ihtiyaçlar kiminde ağırlıklı olarak glüten içeren tahıl kaynakları yönünde olabilirken kiminde sebze ağırlıklı, kiminde ise belli yağ kaynakları veya protein kaynakları üzerinden ilerledi. Altı hafta sonunda yine her iki gruptan dışkı örnekleri toplandı ve ilk örneklerle karşılaştırmalı olarak mikrobiyom analizlerini gerçekleştirildi.” dedi.
Çalışma uluslarası bir kongrede sunulacak
Ufuk Nalbantoğlu, çalışmanın sonuçlarına ilişkin olarak da şu ifadeleri kullandı: “Çalışmanın sonuçlarına ilşEş zamanlı olarak, çalışmada yer alan Gastroenteroloji uzmanları tarafından hastaların klinik durumları 6 hafta boyunca takip edildi ve diyet öncesi sonrası olacak şekilde skorlandı (IBS-SSS). Çalışma sonunda hem mikrobiyom profili hem de klinik bulgular bazında ENBIOSIS diyet grubunda standart diyet grubuna göre istatistiki olarak anlamlı oranda iyileşmeler gözlemledik. Çalışma başlangıcında tüm hastalarda şiddetli semptomlar varken ENBIOSIS diyet grubunun %78’inde semptomların ağırdan ortaya gerilediği Gastroenteroloji uzmanları tarafından raporlandı. Benzer şekilde, ENBISOS diyet grubunda yer alan hastaların mikrobiyom profilinde IBS ile karekterize belli bakteri gruplarında diğer gruba göre anlamlı değişimler olduğu tespit edildi. Bu sonuçları en kısa zamanda bilimsel alanda duyurmak istiyoruz. Ekip olarak makale yazımına başladık, yayından önce sonuçlarımızı bir uluslararası kongrede sunma planımız var.”
Kişiye özel sağlık çözümlerinin gücü kanıtlandı
Bağırsak mikrobiyomu üzerinden hastalıklardan korunma ve tedavi desteği yaklaşımlarını yaygınlaştırmayı amaçladıklarını vurgulayan Nalbantoğlu, “Son yıllarda artan sayıda bilimsel çalışmalar bağırsaklarda yer alan bakteri dengesinin birçok hastalıkla ilişkili olduğuna işaret ediyor. ENBIOSIS olarak literatür verilerinden ve güncel çalışmalardan hareketle crohn, ülseratif kolit, huzursuz bağırsak sendromu, obezite, egzama gibi hastalıkların tedavi süreçlerine kişiselleştirilmiş diyetler ile destek olmayı amaçlıyoruz. Bu doğrultuda ilk aşamada bağırsaktaki bakterileri analiz ederek mevcut durumu haritalıyoruz ve sonrasında sağlıklı olana ulaşmak ya da bakteriyel denge sağlamak için kişisel bazda ihtiyaç duyulan besin öğelerini saptıyoruz. IBS üzerine yaptığımız klinik çalışmada ile literatür için önemli bir gelişmeye imza attığımızı düşünüyoruz. Bu çalışma özellikle mikrobiyoma dayalı kişiye özel sağlık çözümlerinin gücünü kanıtlar nitelikte olması bakımından gurur verici. ENBIOSIS’in başarıları global arenada da yakından takip ediliyor. Son olarak NN sigortanın düzenlediği “When Healthtech Meets Insurance” etkinliğinde 114 global start-up arasından 1. seçildik” şeklinde konuştu.






